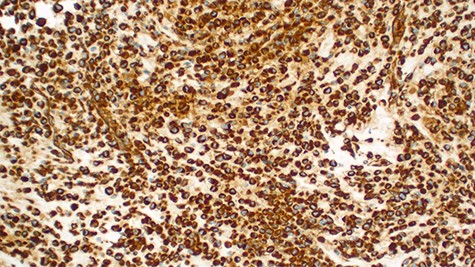
Strongly positive for vimentin immunohistochemistry staining of the tumor cells (×100).

-
PDF
- Split View
-
Views
-
Cite
Cite
Alex Mremi, Jeremia J Pyuza, Nicholas Bartholomeo, Alice A Andongolile, James J Yahaya, Diagnosis of primary osteosarcoma of the urinary bladder in a resource-limited setting: a case report and review of the literature, Journal of Surgical Case Reports, Volume 2020, Issue 7, July 2020, rjaa236, https://doi.org/10.1093/jscr/rjaa236
Close - Share Icon Share
Abstract
Extraskeletal osteosarcoma is a rare malignant mesenchymal soft tissue tumor without attachment to the bone and is able to produce osteoid or cartilaginous matrix. Rendering a definitive diagnosis may pose a challenge particularly in a resource-limited setting. We report a case of primary osteosarcoma of the urinary bladder presenting with hematuria, dysuria and positive history of schistosomal contact. Computed tomography intravenous urogram revealed a large heterogeneous mass at the right superolateral aspect of the urinary bladder. Morphological evaluation of the biopsy and a minimal panel of immunohistochemical antibodies of vimentin and cytokeratin 20 ruled out potential differentials and thus confirmed the diagnosis of osteosarcoma.
INTRODUCTION
Primary urinary bladder osteosarcoma accounts for <0.04 of all urinary bladder malignancies [1]. The tumor is mostly seen in males as compared to females in a ratio of 2:1 [2]. Risk factors are not well known; however, the disease has been linked to exposure to some chemicals, schistosomiasis infection and radiation exposure. Macroscopic hematuria and dysuria are the most common symptoms [2]. Morphological diagnosis may pose a challenge particularly in a resource-limited setting [3]. Herein, we report the case of a 51-year-old male with advanced primary urinary bladder osteosarcoma and brief review of the literature.
CASE REPORT
A 51-year-old man presented to our center with a 2-year history of painful urination and flank pain associated with hematuria. He reported to be smoking and being treated severally for schistosomiasis and urinary tract infection. On physical examination, he was weak and wasted. His vital signs include the following: body temperature, blood pressure, pulse rate and respiratory rate were 36.2°C, 130/87 mm Hg, 80 beats/minute and 20 beats/minute, respectively. The abdomen examination showed a palpable mass at the suprapubic area which was fixed and tender on palpation.
Laboratory investigations revealed a low platelet level of 53 per microliter and hemoglobin level of 10.7 g/dl. Renal profile, white blood count and serum electrolytes were within normal range. Computed tomography intravenous urogram revealed a large heterogeneous mass, measuring 5.5 × 4.5 cm at the right superolateral aspect of the urinary bladder with ipsilateral hydronephrosis and hydroureter. Bone scan study was unremarkable. Urothelial cell carcinoma of the urinary bladder was clinically suggested as the most likely differential diagnosis. Cystoscopy was done under spinal anesthesia, which revealed a solid mass with areas of necrosis at the anterior bladder wall. The biopsy was taken whose histological evaluation revealed a high-grade malignant mesenchymal tumor made up of oval or spindle cells with osteoid formation in many areas of the lesion (Fig. 1). No definite carcinomatous component was appreciated. The tumor was strongly positive for vimentin immunohistochemistry staining (Fig. 2) and negative for cytokeratin 20. Calcified schistosomal ova were also seen (Fig. 3).

Histopathology of urinary bladder tumor showing oval- to spindle-shaped cells with abundant osteoid matrix deposition (H&E stain, ×200).
Strongly positive for vimentin immunohistochemistry staining of the tumor cells (×100).

Calcified schistosomal ova near or within the tumor (H&E ×400).
After a tumor board discussion, a radical cystectomy (Fig. 4) with MAINZ II urinary diversion was performed upon obtaining the patient’s written informed consent. Intraoperative findings were a bladder mass with limited mobility and part of the sigmoid colon ~4 cm was adhered to the mass. Resection of part of the sigmoid colon and end-to-end anastomosis were done. Homeostasis was achieved and abdomen was closed in layers. A pathologic stage of pT4N0M1 was given. Postoperative treatment included intravenous 100 mg of pethidine after every 8 hours for 24 hours, 500 mg of metronidazole three times a day for 5 days, 1 g of ceftriaxone once a day for 5 days and rectal tube for 7 days. The histological findings of the tumor in the radical cystectomy specimen were similar to that in the incisional biopsy with colonic metastasis (Fig. 5). On the 10th day after operation, the patient could pass urine and stool well, and his condition was fairly improving. He was referred to the oncology department for chemotherapy. Unfortunately, the patient developed and died of sepsis before the initiation of oncological treatment.

Cystectomy specimen with a large polypoid tumor with an inward growth causing narrowing of the bladder cavity.

Histopathology of the urinary bladder osteosarcoma metastasizing into the colon. Adjacent normal colon mucosa is seen near the tumor (H&E ×200).
DISCUSSION
Primary extraskeletal osteosarcoma is an extremely rare mesenchymal malignant tumor which is associated with osteoid matrix formation and/or chondroblastic component, without demonstrable attachments to the bone [4]. The tumor does not occur in young patients as it is for osteogenic sarcoma and represents 2–5% of osteosarcomas [5, 6].
A number of risk factors for primary extraskeletal osteosarcoma have been reported in the literature. Radiotherapy, schistosomal infection, trauma, diverticulitis, use of chemotherapy agents such as cyclophosphamide and frequent urinary tract infections have been implicated [1, 6]. Our patient had schistosomiasis (Fig. 3) which might have been the predisposing risk factor.
The diagnosis of primary urinary bladder osteosarcoma may pose challenges because of the morphological resemblance with other tumors. Immunohistochemistry is essential for a definitive diagnosis. The diagnosis has been suggested based on three criteria as it was stated in the study by Allan et al.: (1) presence of a uniform morphological pattern of sarcomatous tissue that excludes the possibility of mixed malignant mesenchymal tumor; (2) production by sarcomatous tissue of malignant osteoid or bone (or both); and (3) ready exclusion of osseous origin [7–10].
Primary urinary bladder osteosarcoma typically is a high-grade tumor; only very few low-grade cases have been reported in the literature [6]. The differential diagnoses include sarcomatoid variant of urothelial carcinoma, urothelial carcinoma with osseous metaplasia, carcinoma with pseudosarcomatous stromal reaction, malignant fibrous histiocytoma, synovial sarcoma and epithelioid sarcoma and bladder carcinosarcoma [1]. A diagnosis of primary urinary bladder osteosarcoma can only be made after excluding possibilities of other malignancies.
Treatment of primary urinary bladder osteosarcoma mainly involves cystectomy. Studies have shown that it responds poorly with chemotherapy and is radiosensitive [1]. Its prognosis is worse than that of osteogenic osteosarcoma, with most patients dying from the disease within 6 months [4]. The tumor tends to be locally aggressive and metastasis is also common and patients may have metastasis at presentation. Approximately 88% of the patients with this tumor tend to have metastasis of the disease to the lungs similar to those with osteogenic osteosarcoma [6]. Our patient had colonic metastasis.
CONCLUSION
Primary urinary bladder osteosarcoma is a rare tumor whose diagnosis may pose a challenge if ancillary tests such as immunohistochemistry are not adequately available. A minimal panel of vimentin and cytokeratin 20 immunohistochemistry may confidently differentiate this tumor from others with similar morphology.
AUTHORS’ CONTRIBUTIONS
A.M. had the original study idea and designed the study. A.M., J.J.P., N.B. and A.A.A. participated in data collection and data presentations. A.M. and J.J.Y. took responsibility of the initial draft of the paper. All authors participated in editing and approved the final version of the manuscript before submission.
DECLARATIONS
ETHICS APPROVAL AND CONSENT TO PARTICIPATE
A written informed consent from the patient to use his information and images to be published was provided by the patient’s family, and a copy is available for review if requested by editor’s office.
CONSENT FOR PUBLICATION
The consent for publication was obtained along with an informed consent from the patients’ family.
AVAILABILITY OF DATA AND MATERIALS
All the information included in the current study is available from the corresponding author upon editorial office’s request.
CONFLICT OF INTEREST STATEMENT
None declared.
FUNDING
No any fund obtained.
ACKNOWLEDGMENTS
We acknowledge the patient in this study for allowing his information to be used for academic and publication.